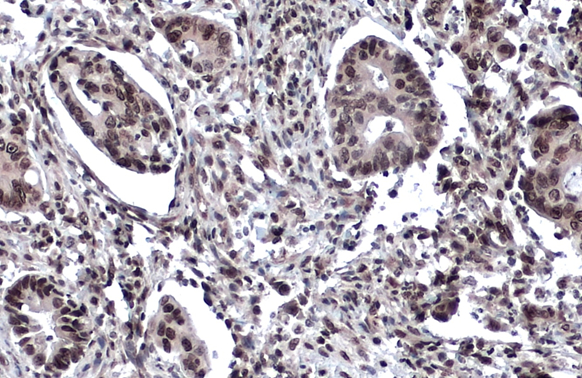
53BP1 antibody detects 53BP1 protein at nucleus by immunohistochemical analysis. Sample: Paraffin-embedded human colon cancer. 53BP1 stained by 53BP1 antibody (GTX70310) diluted at 1:4000. Antigen Retrieval: Citrate buffer, pH 6.0, 15 min 53BP1 antibody detects 53BP1 protein at nucleus by immunohistochemical analysis. Sample: Paraffin-embedded human colon cancer. 53BP1 stained by 53BP1 antibody (GTX70310) diluted at 1:4000. Antigen Retrieval: Citrate buffer, pH 6.0, 15 min

Non-transfected (–) and transfected (+) HeLa whole cell extracts (50 μg) were separated by 5% SDS-PAGE, and the membrane was blotted with 53BP1 antibody (GTX70310) diluted at 1:500. The HRP-conjugated anti-rabbit IgG antibody (GTX213110-01) was used to detect the primary antibody.
53BP1 antibody
GTX70310
ApplicationsImmunoFluorescence, Western Blot, ImmunoCytoChemistry, ImmunoHistoChemistry, ImmunoHistoChemistry Paraffin
Product group Antibodies
ReactivityHuman, Mouse
TargetTP53BP1
Overview
- SupplierGeneTex
- Product Name53BP1 antibody
- Delivery Days Customer9
- Application Supplier NoteSuggested starting dilutions are as follows: WB: 1:500-1:3000, ICC/IF: 1:100-1:1000. Not yet tested in other applications. Optimal working dilutions should be determined experimentally by the end user.
- ApplicationsImmunoFluorescence, Western Blot, ImmunoCytoChemistry, ImmunoHistoChemistry, ImmunoHistoChemistry Paraffin
- CertificationResearch Use Only
- ClonalityPolyclonal
- Concentration0.94 mg/ml
- ConjugateUnconjugated
- Gene ID7158
- Target nameTP53BP1
- Target descriptiontumor protein p53 binding protein 1
- Target synonyms53BP1, TDRD30, p202, p53BP1, TP53-binding protein 1, p53-binding protein 1, tumor protein 53-binding protein, 1, tumor suppressor p53-binding protein 1
- HostRabbit
- IsotypeIgG
- Protein IDQ12888
- Protein NameTP53-binding protein 1
- Scientific DescriptionP53-binding protein 1 (53BP1) plays a critical role in tumor suppression and is a putative substrate of ATM kinase. Upon DNA damage, it is phosphorylated and relocalizes to the presumptive sites of damage, specifically, double-strand breaks. This also suggests a role in DNA repair, maintaining genomic stability.
- ReactivityHuman, Mouse
- Storage Instruction-20°C or -80°C,2°C to 8°C
- UNSPSC41116161

![53BP1 antibody detects 53BP1 protein at nucleus by immunofluorescent analysis. Sample: HeLa cells were fixed in ice-cold MeOH for 5 min. Green: 53BP1 stained by 53BP1 antibody (GTX70310) diluted at 1:500. Red: alpha Tubulin, a cytoskeleton marker, stained by alpha Tubulin antibody [GT114] (GTX628802) diluted at 1:500. Scale bar= 10 μm. 53BP1 antibody detects 53BP1 protein at nucleus by immunofluorescent analysis. Sample: HeLa cells were fixed in ice-cold MeOH for 5 min. Green: 53BP1 stained by 53BP1 antibody (GTX70310) diluted at 1:500. Red: alpha Tubulin, a cytoskeleton marker, stained by alpha Tubulin antibody [GT114] (GTX628802) diluted at 1:500. Scale bar= 10 μm.](https://www.genetex.com/upload/website/prouct_img/normal/GTX70310/GTX70310_43621_20200219_ICC_IF_w_23061221_100.webp)








